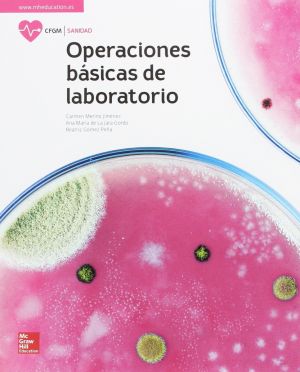

McGraw-Hill
- LA FISICA 1 BATXILLERATAñadir a la Lista de DeseosNo está disponible
- LA OPERACIONES BASICAS DE LABORATORIO. GM.Añadir a la Lista de DeseosNo está disponible
- QUIMICA 1 BATXILLERATAñadir a la Lista de DeseosNo está disponible
- LA TECNOLOGIA INDUSTRIAL 2 BATXILLERAT. CATALUNYA.Añadir a la Lista de DeseosNo está disponible
-
-
- LA Dispensacion de productos farmaceuticos. GMAñadir a la Lista de DeseosNo está disponible
- Música Clave B 2º Eso - CastellanoAñadir a la Lista de DeseosNo está disponible
- FÍSICA Y QUÍMICA 1 Bachillerato., (ANDALUCÍA):Añadir a la Lista de DeseosNo está disponible
- Música Clave B. Valencià. Alumne. 2N ESOAñadir a la Lista de DeseosNo está disponible
Escribenos por WhatsApp